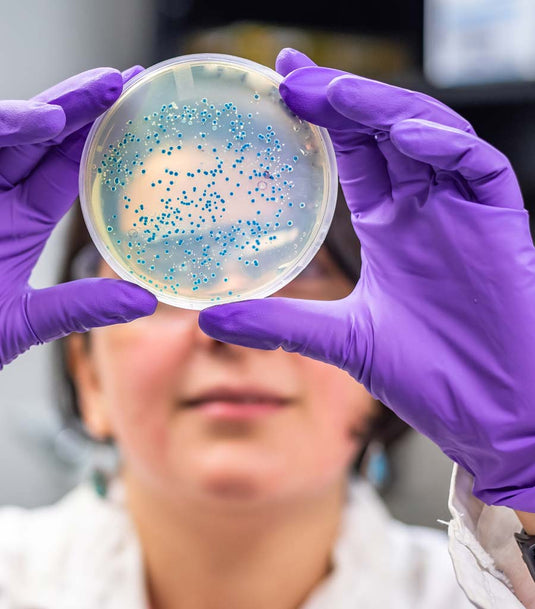
The soil and the human microbiota

Something strange has happened in the fevered world of dietary debate over the last few...
The healthiest diet in the world?
Emotions and heart disease
Chinese medicine has taught for over two thousand years that excessive or prolonged emotions can...
Modern humans with age-old physiologies
We are modern humans. We can work and play throughout the night in 24-hour cities,...
Reducing calories increases health and longevity
This is the special method of lengthening the years and eating for old age.
The soil and the human microbiota
When the right balance of gut bacteria is destroyed by antibiotics, poor diet and disease,...
Mushroom magic
Mushrooms are a mysterious and magical food and medicine – prized in most traditional cultures...
It’s better to light a candle than curse the darkness
Let’s embrace these vital human qualities in our own lives and weigh up our teachers and...
Keep on moving: The vital importance of free flow
A million words can be written about many different ways it benefits the body-mind, but...